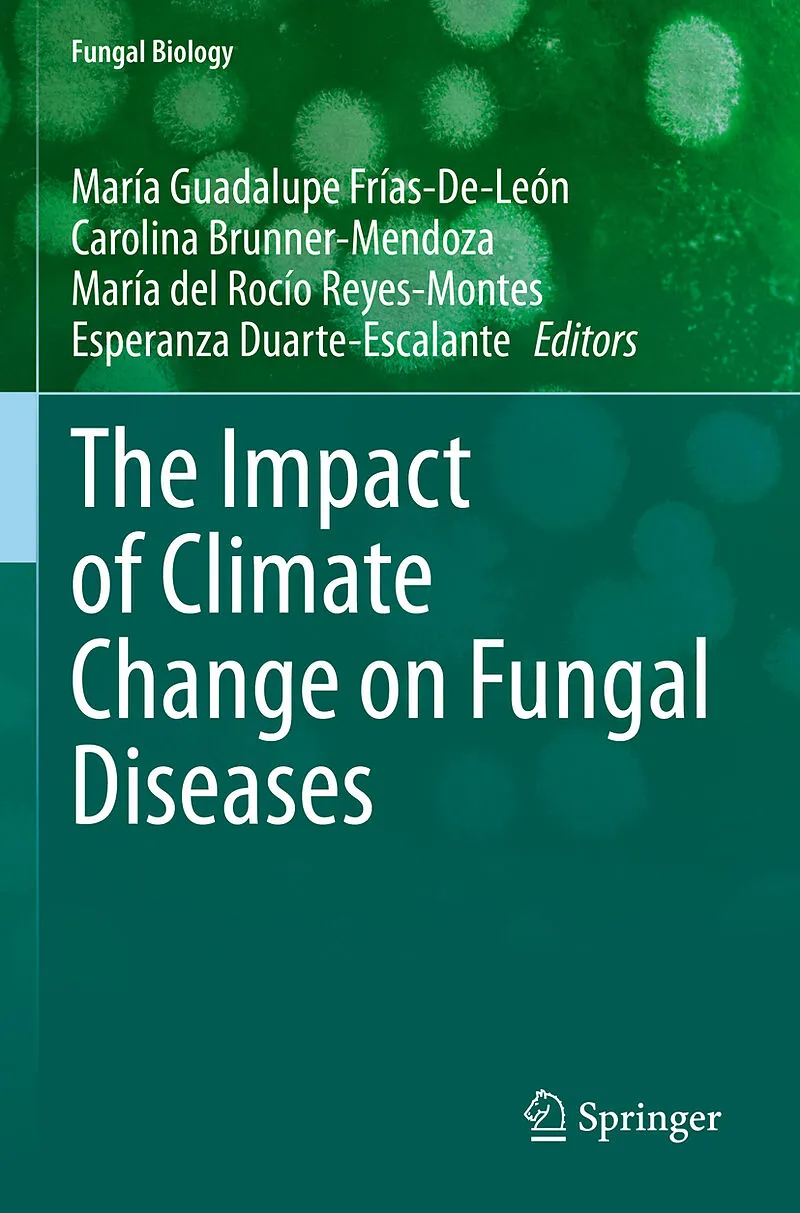

Beschreibung
The shift of weather patterns has affected the incidence and prevalence of infectious diseases, including mycoses. Mycoses have remained neglected due to a lack of training and recognition within the medical community. Nonetheless, these diseases remain common...The shift of weather patterns has affected the incidence and prevalence of infectious diseases, including mycoses. Mycoses have remained neglected due to a lack of training and recognition within the medical community. Nonetheless, these diseases remain common worldwide while frequently being underdiagnosed.
Climate change affects the distribution of fungal communities, provoking outbreaks in locations where these mycoses were absent or in low frequencies. Moreover, the reports of clinical cases related to new fungal pathogens have increased due to the description of new fungal species or due to the ability of some species to shift to new hosts.
Thus, this book, The Impact of Climate Change on Fungal Diseases , is a contribution to the knowledge of a global environmental phenomenon and its relation to these diseases, and it serves as a guide for health professionals to dive deep into the repercussions of climate changeand how they can implement measures for the prevention and control of fungal infections.
Enriches understanding of the underdeveloped field of mycoses Maximizes reader insight into the ways climate change impacts the distribution of pathogenic fungal communities Illustrates how to implement measures for the prevention and control of fungal infections
Autorentext
María Guadalupe Frías-De-León received a doctorate in Biological Sciences in 2012, from Universidad Nacional Autónoma de México (UNAM). She is a researcher in Medical Sciences at the Regional Hospital of High Specialty of Ixtapaluca, and is a professor of Medical Mycology at the UNAM, Mexico. She belongs to the National System of Researchers Level 1, Mexico. Her research is directed at opportunistic pathogenic fungi, especially Candida spp., addressing issues of diagnosis and molecular epidemiology.
Carolina Brunner-Mendoza Associated Professor in the Department of Microbiology and Parasitology, Universidad Autónoma de México (UNAM), Mexico. Her research studies include phylogenetics of entomopathogenic fungus and analysis of airborne microbiome. She is currently working on the molecular epidemiology of sporotrichosis.
María del Rocío Reyes-Montes Professor of Universidad Nacional Autónoma de México (UNAM) since 1997. She received his degree in Pharmacobiological Chemistry in 1977, the degree of MD (Immunology) in 1982 and the doctorate in Biomedical Sciences in 1993 by the UNAM. Her research with fungi has focused on Molecular Epidemiology of pathogenic fungi, obtaining molecular markers for the identification and typification of pathogenic fungi and Molecular diagnosis of pathogenic fungi, especially with the Aspergillus and Coccidioides fungal models and he is currently working on molecular epidemiology of Dermatophytes.
Esperanza Duarte-Escalante obtained the degree of Dra. in Biological Sciences in 2014. She works at the Faculty of Medicine of the Universidad Nacional Autónoma de México (UNAM) and has the appointment of Titular Academic Technician "C" and Associate Professor. She has directed a bachelor's thesis and social service. She has participated as a visiting professor in graduate courses and has been a member of tutorial committees for graduate students. She has participated as an invited reviewer in scientific journals. She has participated in 32 articles published in international scientific journals with impact factor. She belongs to the Program of Premiums for the Performance of Full-Time Academic Personnel (PRIDE) granted by the DGAPA-UNAM, with level "D", in addition belongs to the National System of Researchers Level 1. She has worked fundamentally in the lines of research "Molecular epidemiology of pathogenic fungi" and "Obtaining molecular markers for the diagnosis of pathogenic fungi", mainly focused on the models Aspergillus spp., Coccidioides spp. and dermatophytes.
Inhalt
Preface.- Climate change overview.- Fungi: Essential elements in ecosystems.- Thermotolerance and adaption to climate change.- Impact of climatic change on dermatophytosis.- Climate change and the proliferation of cases of sporotrichosis.- Climate change and eumycetoma.- Effect of climate change on the geographical distribution of coccodioidomycosis.- Geographical expansion of histoplasmosis and its relation to climate change.- Impact of climate change on opportunistic mold infections.- The emergence of opportunistic yeast infections and climate change.- Climate change and allergies.- Climate change and mycotoxins.- Mycosis in natural disasters associated with climate change.- Advances and limitations in the identification of fungi.- Actions against the increase in fungal infections due to climate change: Prospects for vaccine development.- Bibliography.- Index.